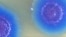
Геном за тысячу долларов

Автор Дмитрий Крылов
-
![Лазерная пуля]() Февраль 08, 2012
Февраль 08, 2012Лазерная пуля
О высокотехнологичных вооружениях
-
![«Парниковая» карта США]() Январь 25, 2012
Январь 25, 2012«Парниковая» карта США
Цифровые технологии на службе EPA
-
![Облачные вычисления]() Декабрь 14, 2011
Декабрь 14, 2011Облачные вычисления
Плюсы и минусы тенденции
-
![Apple TV: очень умный телевизор]() Ноябрь 02, 2011
Ноябрь 02, 2011Apple TV: очень умный телевизор
Есть ли будущее у «обычных» ТВ?
-
![Сенсорный экран, который всегда с тобой]() Октябрь 19, 2011
Октябрь 19, 2011Сенсорный экран, который всегда с тобой
OmniTouch на ладони
-
![内蒙古锡林郭勒大草原]() Октябрь 12, 2011
Октябрь 12, 2011Как покорить мир, не выходя из дома
nginx – маленький большой сервер